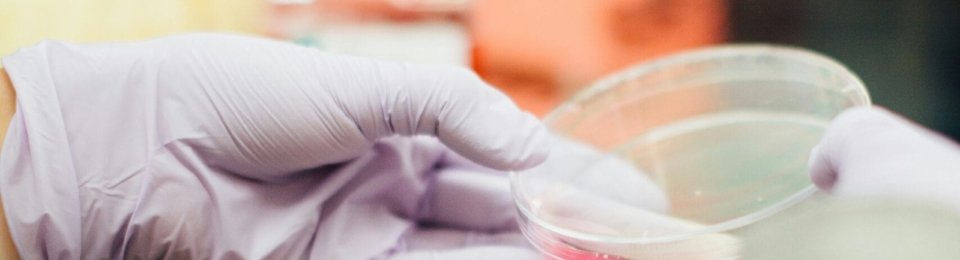
person holding round clear container

Muffato e Max Atacadista – Clientes Cooltec
A Muffato e Max Atacadista também resolveram se juntar à lista de clientes satisfeitos Cooltec!View this post on Instagram A post shared by Cooltec (@cooltec.agro)
Nebulização para carnes e peixes
Quando pensamos em nebulização, geralmente associamos essa tecnologia à conservação de frutas, legumes e verduras (FLV). No entanto, a nebulização também pode ser uma ferramenta poderosa para manter carnes e peixes frescos, atrativos e seguros para ...
Investir em nebulização custa menos do que você imagina
Muitos donos de supermercados e estabelecimentos do setor de hortifrúti hesitam ao considerar a implementação de sistemas de nebulização, imaginando que essa tecnologia seja cara ou complexa. No entanto, a verdade é que investir em nebulizadores par ...
O segredo dos supermercados que mais lucram com FLV
No setor de supermercados, o segmento de Frutas, Legumes e Verduras (FLV) é um dos mais estratégicos para atrair clientes e aumentar as vendas. No entanto, nem todos os estabelecimentos conseguem transformar esse setor em uma fonte lucrativa. Os sup ...
Como evitar que as frutas fiquem ressecadas no hortifrúti?
Manter as frutas frescas e hidratadas é um desafio comum para supermercados e estabelecimentos de hortifrúti. Quando expostas por longos períodos, elas podem perder sua umidade natural, ficando ressecadas e menos atrativas para os consumidores. Além ...
3 Dicas para o sucesso nas vendas do seu hortifrúti
No competitivo mercado de hortifrúti, garantir que os produtos sejam frescos, bem organizados e atrativos é essencial para aumentar as vendas e conquistar a fidelidade dos clientes. Se você quer transformar seu negócio e alcançar o sucesso, confira ...
Como manter folhagens hidratadas e frescas no hortifruti?
Manter folhagens, como alface, rúcula e couve, hidratadas e frescas é um desafio constante para supermercados e estabelecimentos do setor de hortifrúti. Afinal, o frescor desses produtos não só atrai os olhos dos consumidores, como também garante um ...
Rede Kalimera – Cliente Cooltec
A Rede Kalimera também resolveu se juntar à lista de clientes satisfeitos Cooltec!View this post on Instagram A post shared by Cooltec (@cooltec.agro)
Benefícios do sistema Cooltec para supermercados
No mundo competitivo dos supermercados, a qualidade e a apresentação dos produtos são fatores decisivos para atrair e fidelizar clientes. Quando se trata de frutas, legumes e verduras (FLVs), manter esses alimentos frescos, saudáveis e visualmente a ...
Cooltec no MasterChef Brasil
Tivemos a honra de cuidar dos ingredientes do Hortifruti lá no reality MasterChef, bacana né? Só um equipamento confiável para essa responsabilidade tão importante ☺️Convite especial feito pelo Pão de Açúcar, muito bom recordarmos desse momento!...
Só o Expositor Refrigerado não é suficiente
Quando se trata de manter frutas, legumes e verduras (FLVs) frescos e atraentes nas prateleiras do supermercado ou hortifruti, muitos empresários apostam exclusivamente em expositores refrigerados. Sem dúvida, esses equipamentos são fundamentais par ...
Depoimento de quem usa Cooltec: Supermercados Nagumo
Confira o depoimento de nosso case de sucesso na rede de supermercados Nagumo, onde os nebulizadores da Cooltec fizeram toda a diferença no hortifrúti!View this post on Instagram A post shared by Cooltec (@cooltec.agro)
Como fazer o alface durar mais no hortifruti?
Quem trabalha com hortifrutis sabe que o alface é um dos produtos mais populares nas prateleiras, mas também um dos mais desafiadores quando o assunto é conservação. Por ser uma verdura delicada e altamente perecível, o alface pode murchar rapidamen ...
Nebulizador para Hortifrúti em Goiás
Os nebulizadores são utilizados para controlar a umidade do ambiente, retardando o amadurecimento de frutas, verduras e legumes, e são essenciais para mercados, quitandas e hortifrutis, ajudando a reduzir as perdas e o desperdício.O amadurecimen ...
Câmara Pressurizada para hortifrúti na região de Sorocaba
As câmaras pressurizadas desempenham um papel essencial na conservação dos alimentos, proporcionando um ambiente controlado que favorece a preservação dos alimentos. Esses ambientes controlados evitam a proliferação de micro-organismos, que podem ca ...
Umidificador de frutas e verduras na região de Campinas
Supermercados, quitandas e hortifrútis enfrentam diariamente o desafio de manter os produtos expostos frescos e atrativos por mais tempo. Por isso é muito importante a utilização de tecnologias de controle de frescor e amadurecimento, como umidifica ...